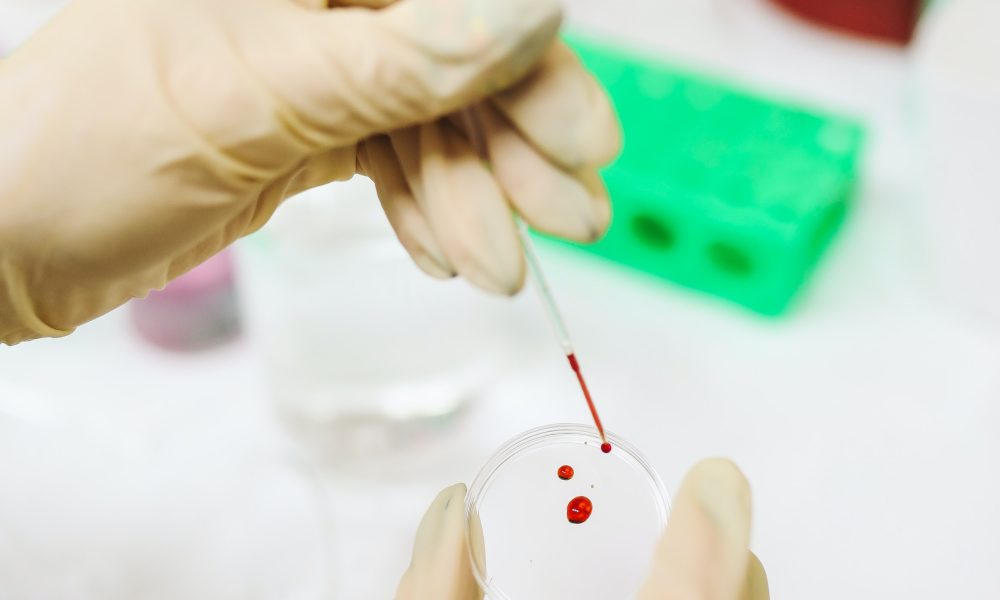
Tipo sanguíneo: A, B, AB e O, qual é o seu?

Descubra como ser um doador de sangue-sacional e salve vidas com um gesto de amor! Seja parte dessa corrente do bem e faça a diferença hoje mesmo! #doesangue #salvevidas #amor #solidariedade
O post Descubra como ser um doador de sangue! apareceu primeiro em Seja Criativo.
]]>

Doar sangue é uma das formas mais nobres de ajudar quem precisa. Infelizmente, a maioria das pessoas tem medo de agulhas ou desconhecem como funciona o processo. Pensando nisso, preparamos este artigo com dicas para você se tornar um doador de sangue e salvar vidas de forma divertida!
Seja um Herói: Descubra como doar sangue!
Doar sangue é um ato simples e rápido que pode salvar vidas. Antes de tudo, é importante saber que existem critérios para ser um doador. Você precisa ter entre 16 e 69 anos, pesar mais de 50kg, estar bem de saúde e ter dormido pelo menos 6 horas na noite anterior. Além disso, é necessário apresentar um documento com foto no momento da doação.
Se você atende a todos os requisitos, basta ir a um hemocentro ou banco de sangue mais próximo e se cadastrar como doador. O processo de doação dura em torno de 30 minutos e é totalmente seguro. Depois de doar, você pode aproveitar para descansar e tomar um lanche oferecido pelo local.
Salve Vidas de Forma Divertida
Doar sangue pode ser uma experiência divertida e gratificante. Alguns bancos de sangue promovem campanhas especiais para incentivar a doação, como eventos com música ao vivo, sorteios de brindes e até mesmo uma mini-sessão de fotos para registrar o momento.
Outra forma de tornar a doação mais divertida é convidar amigos ou familiares para doar junto com você. Além de ser uma ótima oportunidade de passar um tempo juntos, vocês ainda estarão salvando vidas juntos!
Não perca a chance de ser um herói e salvar vidas de forma divertida. Doe sangue e faça a diferença no mundo!
Ser um doador de sangue é um ato de amor ao próximo. Esperamos que este artigo tenha ajudado a esclarecer as dúvidas sobre o processo de doação e que você esteja animado para se tornar um doador. Lembre-se que a doação de sangue é um gesto simples, mas que pode fazer toda a diferença na vida de alguém. Seja um herói e doe sangue!
Então, o que você achou desse artigo sobre como ser um doador de sangue? Comente, compartilhe esse conteúdo e nos siga no Instagram, Facebook e Spotify.
Dessa forma você poderá acompanhar todas as novidades sobre o mundo da criatividade!
O post Descubra como ser um doador de sangue! apareceu primeiro em Seja Criativo.
]]>
Aí vem a letra do sangue! 🅰️🅱️ AB e O, qual é o seu? Descubra a maravilha que é a tipagem sanguínea e celebre a diversidade do nosso sangue com alegria!
O post Tipo sanguíneo: A, B, AB e O, qual é o seu? apareceu primeiro em Seja Criativo.
]]>
Você já se perguntou qual é o seu tipo sanguíneo? Aquele indicado pelas letras A, B e O que aparecem em todo exame médico? A verdade é que muitas pessoas não sabem qual é o seu tipo sanguíneo ou não conhecem as curiosidades por trás da letra do seu sangue. Por isso, vamos desvendar todos os mistérios e descobrir o que o seu tipo sanguíneo pode revelar sobre você!
Chega de mistério: descubra o seu tipo sanguíneo! A, B, AB ou O?
A primeira letra indica o tipo de antígeno presente na superfície das células vermelhas do sangue: A, B, ambos (AB) ou nenhum (O). O segundo indicador é o tipo de anticorpo presente no plasma sanguíneo: anti-A, anti-B, ambos (AB) ou nenhum (O). Então, se você tem o tipo A, significa que tem antígeno A na superfície das suas células vermelhas e anticorpo anti-B no seu plasma. O tipo B é o contrário, com antígeno B e anticorpo anti-A. O tipo AB tem ambos os antígenos e nenhum dos anticorpos, enquanto o tipo O não tem antígenos e tem ambos os anticorpos.
Se você ainda não sabe qual é o seu tipo sanguíneo, é uma informação importante para ter em caso de emergência médica. Você pode descobrir fazendo um simples exame de sangue ou checando o seu cartão de doador de sangue. É importante lembrar que o tipo sanguíneo não muda ao longo da vida, então é uma informação válida para sempre.
Conheça as curiosidades por trás da letra do seu sangue e o que ela pode revelar sobre você! 

Além de ser importante para transfusões de sangue e doações, o tipo sanguíneo também pode revelar informações sobre a sua saúde e personalidade. Por exemplo, pessoas com o tipo O têm menor risco de doenças cardíacas, enquanto pessoas com o tipo AB têm maior risco de problemas gastrointestinais. Também há estudos que relacionam certos tipos sanguíneos com a personalidade, como pessoas do tipo A sendo mais perfeccionistas e do tipo B sendo mais criativas.
Outra curiosidade é que o tipo sanguíneo pode influenciar na escolha do parceiro. Algumas culturas acreditam que casais com tipos sanguíneos compatíveis têm maior chance de ter um relacionamento duradouro e filhos saudáveis. No Japão, por exemplo, é comum verificar o tipo sanguíneo antes de marcar uma entrevista de emprego ou encontro romântico.
Por fim, o tipo sanguíneo pode até influenciar na alimentação. A chamada dieta do tipo sanguíneo indica que cada tipo deve comer certos alimentos e evitar outros, de acordo com a sua resposta imunológica aos antígenos. Por exemplo, pessoas do tipo O devem evitar grãos e laticínios, enquanto pessoas do tipo B devem evitar frango e milho.
Agora que você já sabe qual é o seu tipo sanguíneo e todas as curiosidades por trás da letra do seu sangue, é hora de compartilhar essa informação com amigos e familiares. Além de ser útil em situações de emergência médica, é uma forma divertida de descobrir mais sobre si mesmo e as pessoas ao seu redor. E lembre-se, independentemente do tipo sanguíneo, todos podem ajudar a salvar vidas doando sangue regularmente!
Então, o que você achou desse artigo sobre tipo sanguíneo? Esperamos que tenha gostado deste artigo sobre tipos sanguíneos. Compartilhe com seus amigos e familiares para que eles também possam descobrir seu tipo sanguíneo e ajudar quem precisa. Lembre-se: sangue bom é aquele que corre nas veias e que ajuda a salvar vidas! Comente, compartilhe esse conteúdo e nos siga no Instagram, Facebook e Spotify.
Dessa forma você poderá acompanhar todas as novidades sobre o mundo da criatividade!
O post Tipo sanguíneo: A, B, AB e O, qual é o seu? apareceu primeiro em Seja Criativo.
]]>